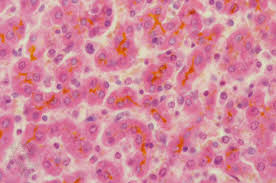
cholestasis of pregnancy singapore pdf ppt case reports symptoms treatment

mr mineral stained extension pregnancy
Look This Also
cells free full text evidence for overlapping and distinct biological activities and transcriptional targets triggered by fibroblast growth factor receptor 2b signaling between mid and early pseudoglandular stages of mouse lung
frontiers salivary microbiome variation in early childhood caries of children 3 6 years of age and its association with iron deficiency anemia and extrinsic black stain cellular and infection microbiology
ijms free full text early pregnancy human decidua is enriched with activated fully differentiated and pro inflammatory gamma delta t cells with diverse tcr repertoires html
ijms free full text early pregnancy human decidua is enriched with activated fully differentiated and pro inflammatory gamma delta t cells with diverse tcr repertoires html
the nasopharyngeal ruminal and vaginal microbiota and the core taxa shared across these microbiomes in virgin yearling heifers exposed to divergent in utero nutrition during their first trimester of gestation and in
ijms free full text early pregnancy human decidua is enriched with activated fully differentiated and pro inflammatory gamma delta t cells with diverse tcr repertoires html
ijms free full text early pregnancy human decidua is enriched with activated fully differentiated and pro inflammatory gamma delta t cells with diverse tcr repertoires html
ijms free full text early pregnancy human decidua is enriched with activated fully differentiated and pro inflammatory gamma delta t cells with diverse tcr repertoires html
https encrypted tbn0 gstatic com images q tbn and9gcsgoxlf9lwbksnvuepwctko3a thb1bzmt vyvrse5mq7ifkd9 usqp cau